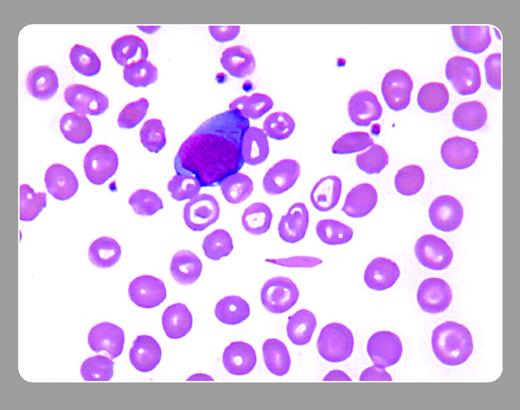
A 66-year-old African American woman with lifelong anemia and a positive family history of anemia came to the emergency room with abdominal pain. Her numerous previous medical problems included intermittent bone pains, infections, and chest pains. When seen, she was writhing in pain and asking for narcotics. Her physical exam showed slight fever, some scleral icterus, and a tender abdomen with normal bowel sounds. . / The clinical picture was thought to be consistent with sickle cell painful crisis, but the white blood cell count was 3.7 × 109/L; granulocyte count, 1.0 × 109/L; and platelet count, 110 × 109/L. In retrospect, granulocytopenia and thrombocytopenia had been evolving over the past several months. A peripheral smear showed sickle forms and targets. Immature cells were also present, some of which contained Auer rods (see above). The bone marrow was hypocellular with megaloblastic changes, but with 15 % leukemic cells. Rather than another diagnosis of painful crisis, she had refractory anemia with excess blasts in transformation (RAEB-T).

A 66-year-old African American woman with lifelong anemia and a positive family history of anemia came to the emergency room with abdominal pain. Her numerous previous medical problems included intermittent bone pains, infections, and chest pains. When seen, she was writhing in pain and asking for narcotics. Her physical exam showed slight fever, some scleral icterus, and a tender abdomen with normal bowel sounds.
The clinical picture was thought to be consistent with sickle cell painful crisis, but the white blood cell count was 3.7 × 109/L; granulocyte count, 1.0 × 109/L; and platelet count, 110 × 109/L. In retrospect, granulocytopenia and thrombocytopenia had been evolving over the past several months. A peripheral smear showed sickle forms and targets. Immature cells were also present, some of which contained Auer rods (see above). The bone marrow was hypocellular with megaloblastic changes, but with 15 % leukemic cells. Rather than another diagnosis of painful crisis, she had refractory anemia with excess blasts in transformation (RAEB-T).
A 66-year-old African American woman with lifelong anemia and a positive family history of anemia came to the emergency room with abdominal pain. Her numerous previous medical problems included intermittent bone pains, infections, and chest pains. When seen, she was writhing in pain and asking for narcotics. Her physical exam showed slight fever, some scleral icterus, and a tender abdomen with normal bowel sounds.
The clinical picture was thought to be consistent with sickle cell painful crisis, but the white blood cell count was 3.7 × 109/L; granulocyte count, 1.0 × 109/L; and platelet count, 110 × 109/L. In retrospect, granulocytopenia and thrombocytopenia had been evolving over the past several months. A peripheral smear showed sickle forms and targets. Immature cells were also present, some of which contained Auer rods (see above). The bone marrow was hypocellular with megaloblastic changes, but with 15 % leukemic cells. Rather than another diagnosis of painful crisis, she had refractory anemia with excess blasts in transformation (RAEB-T).
Many Blood Work images are provided by the ASH IMAGE BANK, a reference and teaching tool that is continually updated with new atlas images and images of case studies. For more information or to contribute to the Image Bank, visit www.ashimagebank.org.